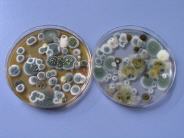

Sie sind hier: >>> Feuchtigkeit & Schimmelpilz
Feuchtigkeit & Schimmelpilz
Zertifizierter Fachbetrieb für Schimmelpilzsanierung
Die Entstehung von Schimmelpilzen hängt eng mit den Temperatur- und Feuchtigkeitsverhältnissen in Innenräumen zusammen. Um ein schimmelfreies Raumklimazu schaffen und gleichzeitig Heizkosten zu sparen, ist neben einer guten Wärmedämmung ein bewusstes Verhalten beim Heizen und Lüften extrem wichtig. Wichtigste Ursache für einen Schimmelpilzbefall ist die anhaltende Feuchtigkeit in und auf einem Bauteil.
Erhöhte Feuchtigkeit oder Luftfeuchtigkeit kann jedoch höchst unterschiedliche Gründe haben:
-Wasserschäden von Außen (Fassade, Fallrohre, Abdichtungen im Erdreich)
-Wasserschäden von Innen (Rohrbrüche, Leckagen, aufsteigende Feuchte etc.)
-Innenraumkondensation im Winter (aufgrund unzureichender Wärmedämmung)
-Innenraumkondensation im Sommer (aufgrund falscher Lüftung)
-Konvektionsschäden (Wasserschäden aufgrund Luftundichtigkeiten z.B. an Dächern)
-Neubaufeuchte
-Falsche Innendämmung (Dämmtapeten, falsche Materialwahl bei Innendämmungen)
Um hier die richtigen Werte zu ermitteln sind Fachgerächte Messungen von Temperatur, Luftfeuchtigkeit, Taupunkt usw. unerlässlich und sollten nur von einer dafür speziell ausgebildeten Fachkraft vorgenommen werden.


